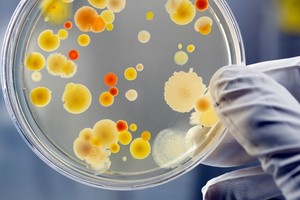

Las ollas quemadas pueden parecer un desafío de limpieza, pero con algunos métodos sencillos puedes restaurarlas a su estado original sin mucho esfuerzo.
Los mejores consejos para limpiar ollas quemadas y devolverles su brillo
Estas soluciones caseras te ayudarán a recuperar el brillo de tus utensilios de cocina sin esfuerzo.


Aquí te presentamos algunas técnicas efectivas para eliminar los residuos quemados y devolverle el brillo a tu olla.
Bicarbonato y agua
Uno de los métodos más fáciles y accesibles es usar bicarbonato de sodio. Este ingrediente común en la cocina tiene propiedades abrasivas suaves que ayudan a desprender los restos quemados sin dañar la superficie de la olla.
Instrucciones:
- Llena la olla con suficiente agua para cubrir el área quemada.
- Añade 2-3 cucharadas de bicarbonato de sodio al agua.
- Lleva a ebullición y deja hervir durante 15-20 minutos.
- Retira del fuego y deja enfriar un poco.
- Usa una esponja para frotar el área. Los residuos deberían desprenderse con facilidad.
- Lava la olla como de costumbre y enjuaga bien.

Vinagre y bicarbonato
El vinagre y el bicarbonato de sodio combinados ofrecen una potente solución para las ollas quemadas. La reacción efervescente entre ambos ingredientes ayuda a soltar los residuos adheridos.
Instrucciones:
- Espolvorea una capa de bicarbonato de sodio en el fondo de la olla.
- Vierte suficiente vinagre blanco para cubrir el bicarbonato.
- Deja que la mezcla efervescente actúe durante 10-15 minutos.
- Usa una esponja para frotar la olla, concentrándote en las áreas quemadas.
- Enjuaga y limpia la olla normalmente.

Sal y limón
La combinación de sal y limón no solo es efectiva para limpiar ollas quemadas, sino que también deja un aroma fresco.
Instrucciones:
- Corta un limón por la mitad y exprímelo en la olla.
- Espolvorea sal gruesa sobre el área quemada.
- Usa la mitad del limón como una esponja para frotar la mezcla de sal y jugo de limón sobre los residuos.
- Deja reposar durante 10 minutos.
- Limpia con una esponja y enjuaga bien.

Consejos adicionales
No uses utensilios metálicos que puedan rayar la superficie de la olla.
Evita productos de limpieza abrasivos que puedan dañar el revestimiento.
Siempre limpia la olla después de usarla para evitar acumulación de residuos y quemaduras.
Con estos métodos, limpiar una olla quemada puede ser mucho más fácil de lo que parece. Con un poco de paciencia y los ingredientes adecuados, puedes devolverle la vida a tus utensilios de cocina y mantenerlos en excelente estado.

Dejanos tu comentario
Los comentarios realizados son de exclusiva responsabilidad de sus autores y las consecuencias derivadas de ellos pueden ser pasibles de las sanciones legales que correspondan. Evitar comentarios ofensivos o que no respondan al tema abordado en la información.